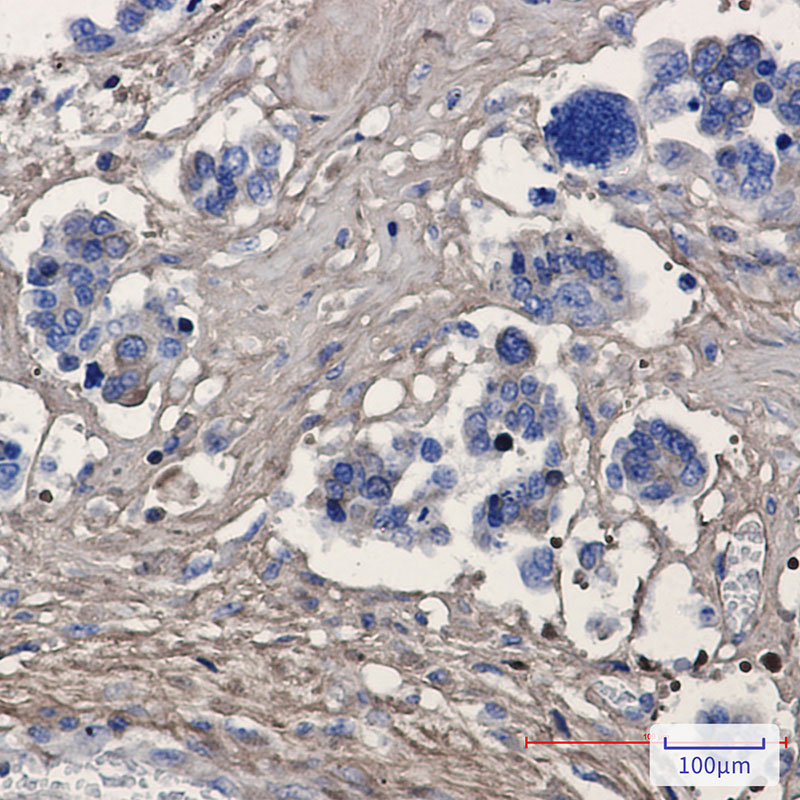

-
分类: 科研抗体货号: P21831别名: PRDX2; NKEFB; TDPX1; Peroxiredoxin-2; Natural killer cell-enhancing factor B; NKEF-B; PRP; Thiol-specific antioxidant protein; TSA; Thioredoxin peroxidase 1; Thioredoxin-dependent peroxide reductase 1应用: WB,IHC反应种属: Human,Mouse,Rat
-
分类: 科研抗体货号: P21815别名: HCHOLA3; LDLCQ1; NARC1; Neural apoptosis regulated convertase 1; PC9; PCSK9; Proprotein convertase 9应用: WB,IP反应种属: Human
-
分类: 科研抗体货号: P21846别名: PI3K; PIK3; PI3CG; PI3Kgamma; p110gamma; p120-PI3K应用: WB,IP反应种属: Human
-
分类: 科研抗体货号: P21830别名: EIF2AK3; PEK; PERK; Eukaryotic translation initiation factor 2-alpha kinase 3; PRKR-like endoplasmic reticulum kinase; Pancreatic eIF2-alpha kinase; HsPEK应用: WB反应种属: Human,Mouse,Rat
-
分类: 科研抗体货号: P21814别名: PTPRQ; EC-PTP; PCPTP1; PTP-SL; PTPBR7应用: WB反应种属: Rat
-
分类: 科研抗体货号: P21845别名: PIK3CB; DKFZp779K1237; MGC133043; PI3K; PI3KCB; PI3Kbeta; PIK3C1; p110-BETA应用: WB,IP反应种属: Human
-
分类: 科研抗体货号: P21829别名: Fasciclin-I like; OSF2; Periostin; Periostin osteoblast specific factor; PN; POSTN; RP11 412K4.1应用: WB,IP,IHC反应种属: Human,Rat
-
分类: 科研抗体货号: P21813别名: PCK2; PEPCK2; Phosphoenolpyruvate carboxykinase [GTP]; mitochondrial; PEPCK-M; Phosphoenolpyruvate carboxylase应用: WB,IHC,IF反应种属: Human,Mouse,Rat
-
分类: 科研抗体货号: P21844别名: Plcb; AI132408; mKIAA0581; 3110043I21Rik应用: WB反应种属: Rat
-
分类: 科研抗体货号: P21828别名: PROLIDASE应用: WB反应种属: Human

鄂公网安备42018502007531号
鄂公网安备42018502007531号

